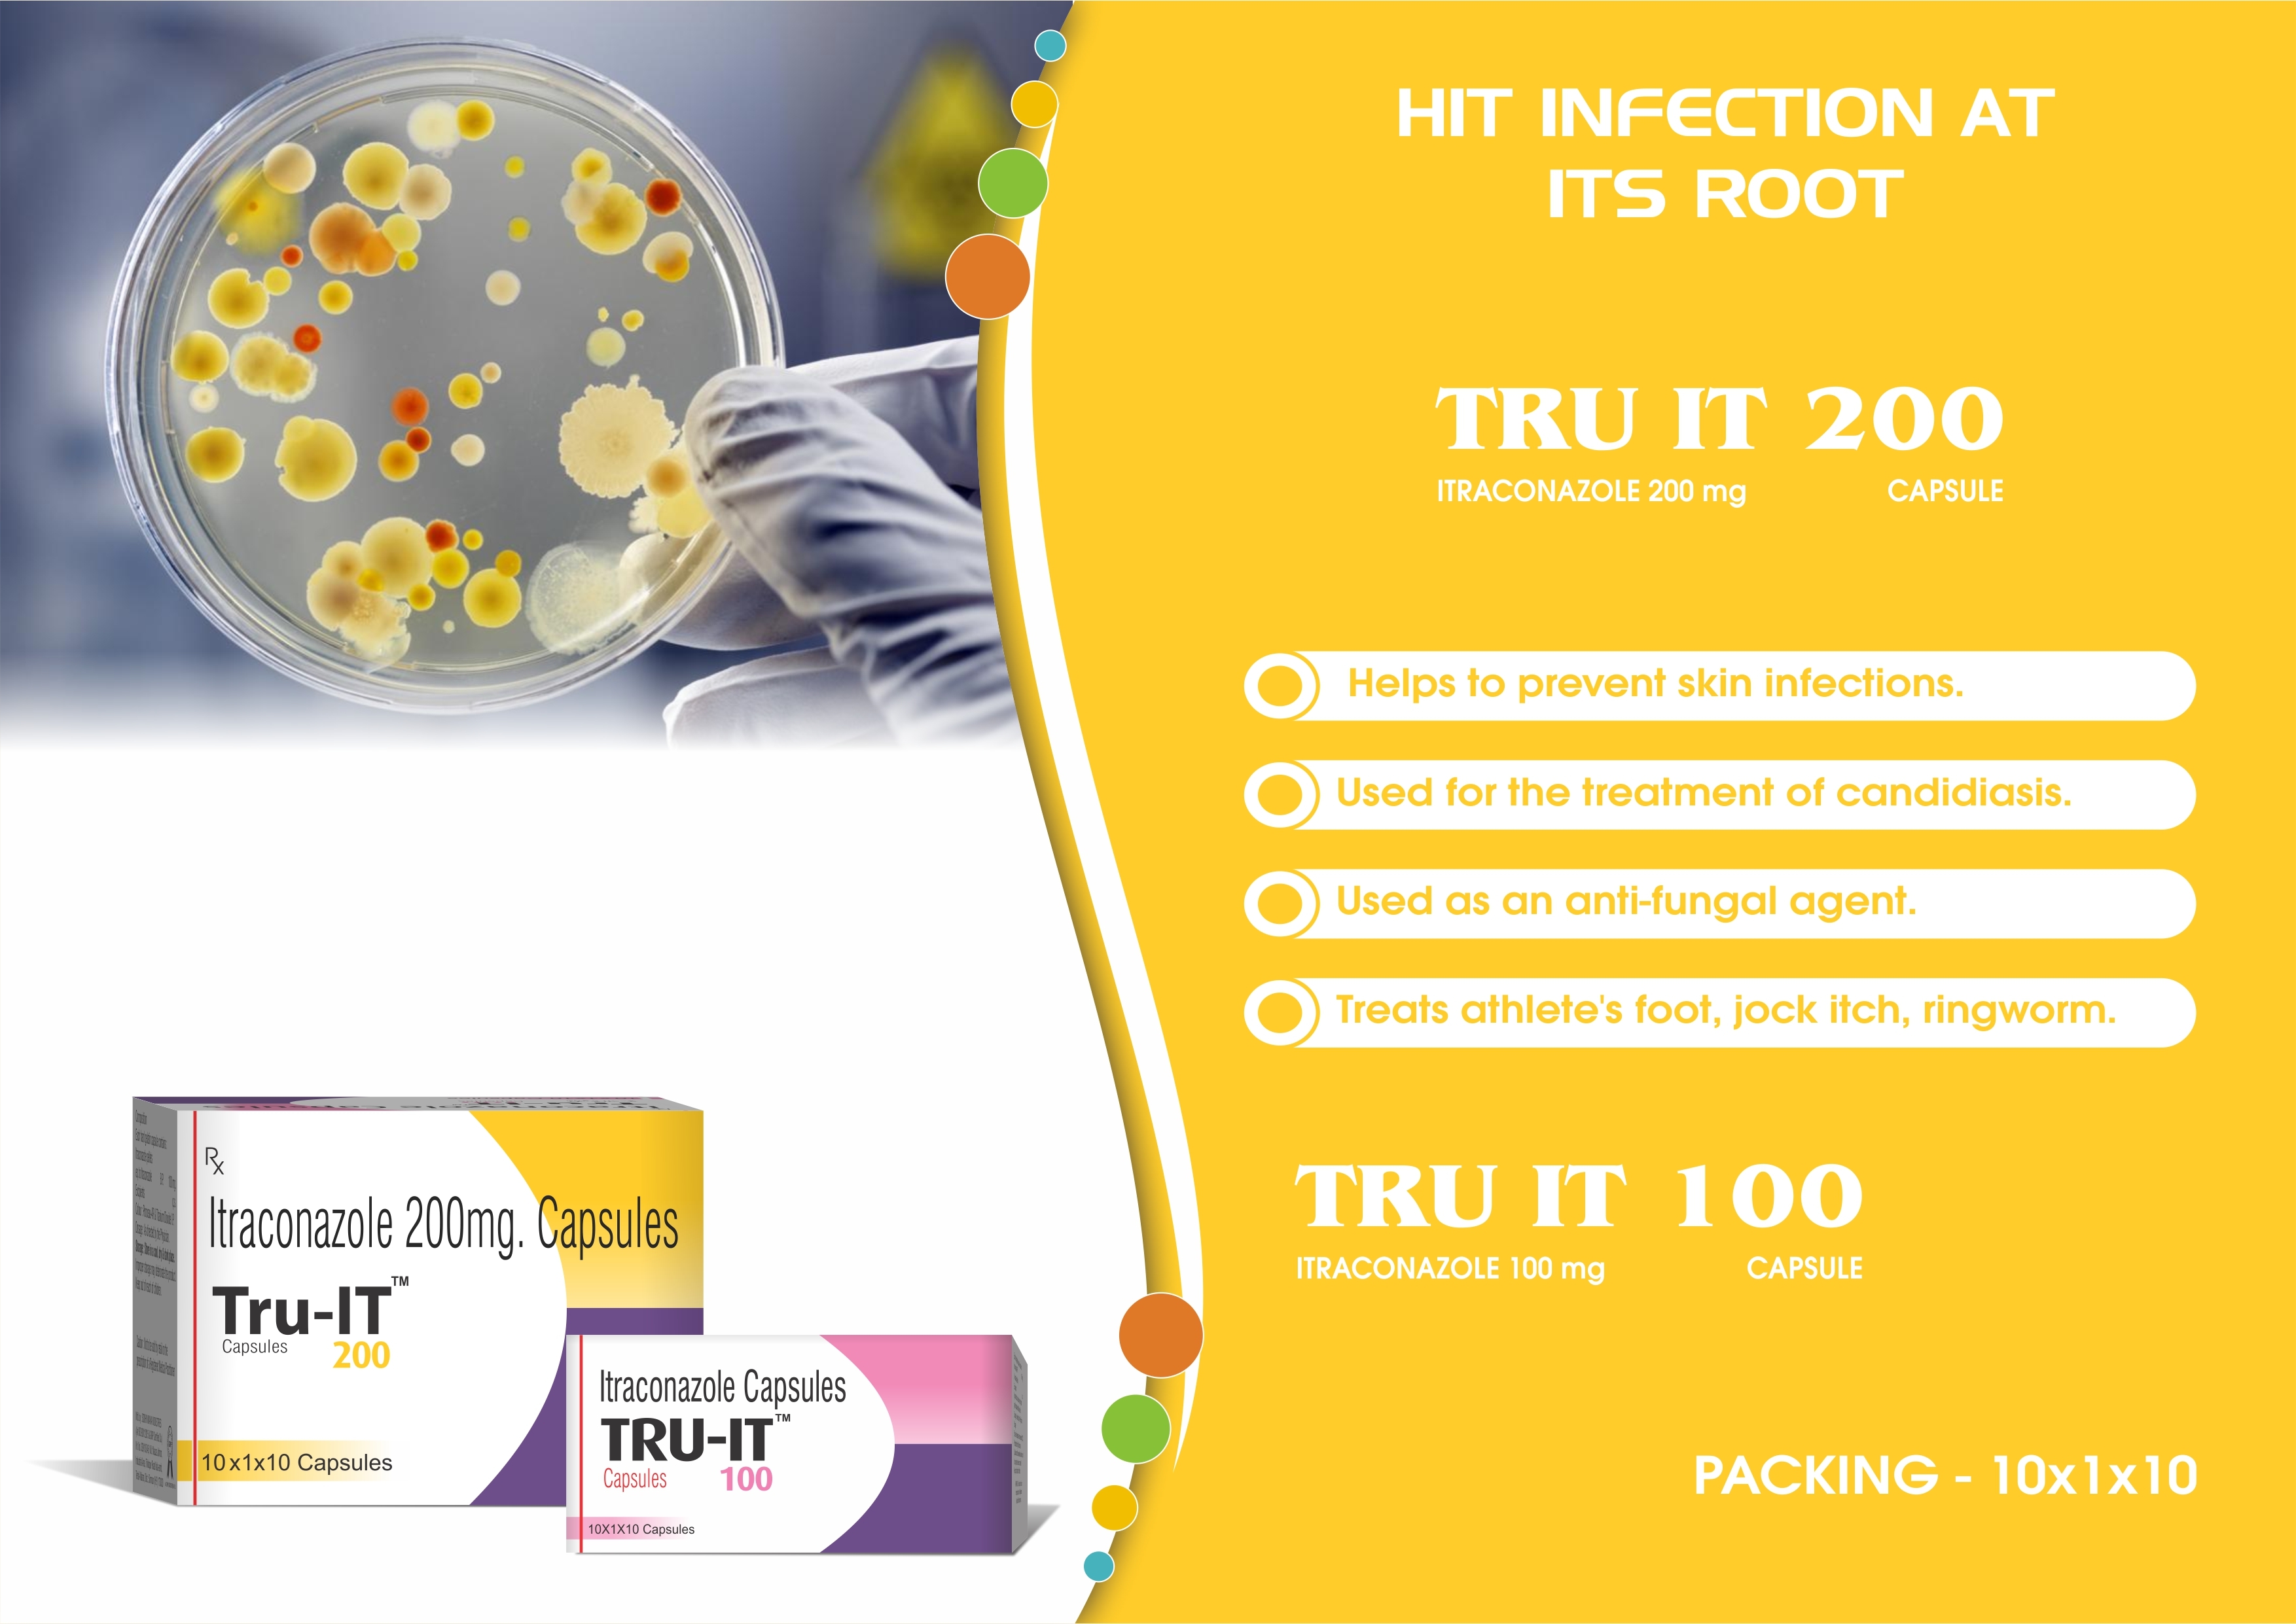
Truworth Tru-it 100

Truworth Tru-it 100
Price:
Get Latest Price
Minimum Order Quantity :
500 Box
Brand Name :
Truworth Healthcare
In Stock
Product Specifications
| Drug | Itraconazole |
| Dosage | 100mg |
| Form | Capsules |
| Packaging | Blister pack |
| Quantity | 10-100 |
| Storage | Room temperature |
| Usage | Treats fungal infections like athlete's foot, jock itch, and ringworm; also used for candidiasis. |
| Features | Anti-fungal, Skin infection, Candidiasis treatment, Athlete's foot, Jock itch, Ringworm |
| Payment Terms | Cash Advance (CA), Cash in Advance (CID) |
| Supply Ability | 500000 Per Month |
| Delivery Time | 40-45 Days |
| Sample Available | Yes |
| Sample Policy | Free samples available with shipping and taxes paid by the buyer |
| Packaging Details | 10*10 packing with outer carton |
| Main Export Market(s) | Australia, North America, Eastern Europe, Western Europe, Middle East, Central America, South America, Asia, Africa |
| Certifications | Available |
Company Details
Business Type
Exporter, Manufacturer, Supplier, Trading Company
Employee Count
58
Establishment
2010
Working Days
Monday To Sunday
GST NO
06BSBPK6000N1ZV
Explore Related Categories
More Product From This seller
Seller Details

GST - 06BSBPK6000N1ZV
Rohtak, Haryana
Managing Director
Mr Girnish Khetarpal
Address
Plot No, 167, Hisar Rd, J.P. Colony, HSIIDC Industrial Area, Rohtak, Haryana, 124001, India
dermatological formulations in Rohtak
Report incorrect details


























